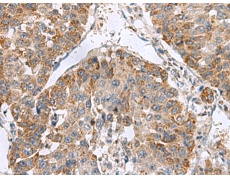
一抗

中文名稱: 兔抗NFS1多克隆抗體
英文名稱: Anti-NFS1 rabbit polyclonal antibody
別 名: NFS1, cysteine desulfurase; IscS; NIFS; HUSSY-08
相關(guān)類別: 一抗
儲 存: 冷凍(-20℃)
宿 主: Rabbit
抗 原: NFS1
反應(yīng)種屬: Human
標(biāo) 記 物: Unconjugate
克隆類型: rabbit polyclonal
技術(shù)規(guī)格
|
Background: |
Iron-sulfur clusters are required for the function of many cellular enzymes. The proteins encoded by this gene supply inorganic sulfur to these clusters by removing the sulfur from cysteine, creating alanine in the process. This gene uses alternate in-frame translation initiation sites to generate mitochondrial forms and cytoplasmic/nuclear forms. Selection of the alternative initiation sites is determined by the cytosolic pH. The encoded proteins belong to the class-V family of pyridoxal phosphate-dependent aminotransferases. Alternatively spliced transcript variants have been described. |
|
Applications: |
ELISA, IHC |
|
Name of antibody: |
NFS1 |
|
Immunogen: |
Fusion protein of human NFS1 |
|
Full name: |
NFS1, cysteine desulfurase |
|
Synonyms: |
IscS; NIFS; HUSSY-08 |
|
SwissProt: |
Q9Y697 |
|
ELISA Recommended dilution: |
5000-10000 |
|
IHC positive control: |
Human liver cancer and Human colorectal cancer |
|
IHC Recommend dilution: |
50-200 |


 購物車
購物車 幫助
幫助
 021-54845833/15800441009
021-54845833/15800441009